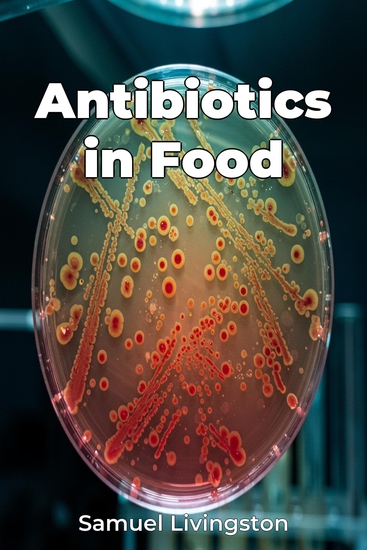

Antibiotics in Food
Samuel Livingston
Übersetzer A AI
Verlag: Publifye
Beschreibung
Antibiotics in Food investigates the widespread use of antibiotics in agriculture and its impact on public health, focusing on how this practice fuels antibiotic resistance. The book explores the drivers behind antibiotic use in food production, the rise of resistant bacteria, and potential mitigation strategies. A key insight is how agricultural antibiotic use, initially adopted post-World War II to boost livestock growth, directly diminishes the effectiveness of antibiotics in treating human infections, threatening our ability to combat diseases. The book argues that routine, non-therapeutic antibiotic use in agriculture significantly contributes to the global antibiotic resistance crisis, necessitating urgent interventions. It thoroughly examines the economic and social factors incentivizing antibiotic use, the scientific evidence linking agricultural practices to the spread of resistant bacteria to humans, and the effects of resistant infections on human health, such as increased healthcare costs. It then proposes solutions like policy changes and alternative farming practices. Structured to guide readers through the issue's complexities, the book begins with fundamental concepts of antibiotic resistance and its mechanisms. It then examines the role of agriculture, covering areas such as livestock farming and aquaculture. The book concludes by presenting potential solutions and discussing practical implications for consumers, policymakers, and the agricultural industry.














